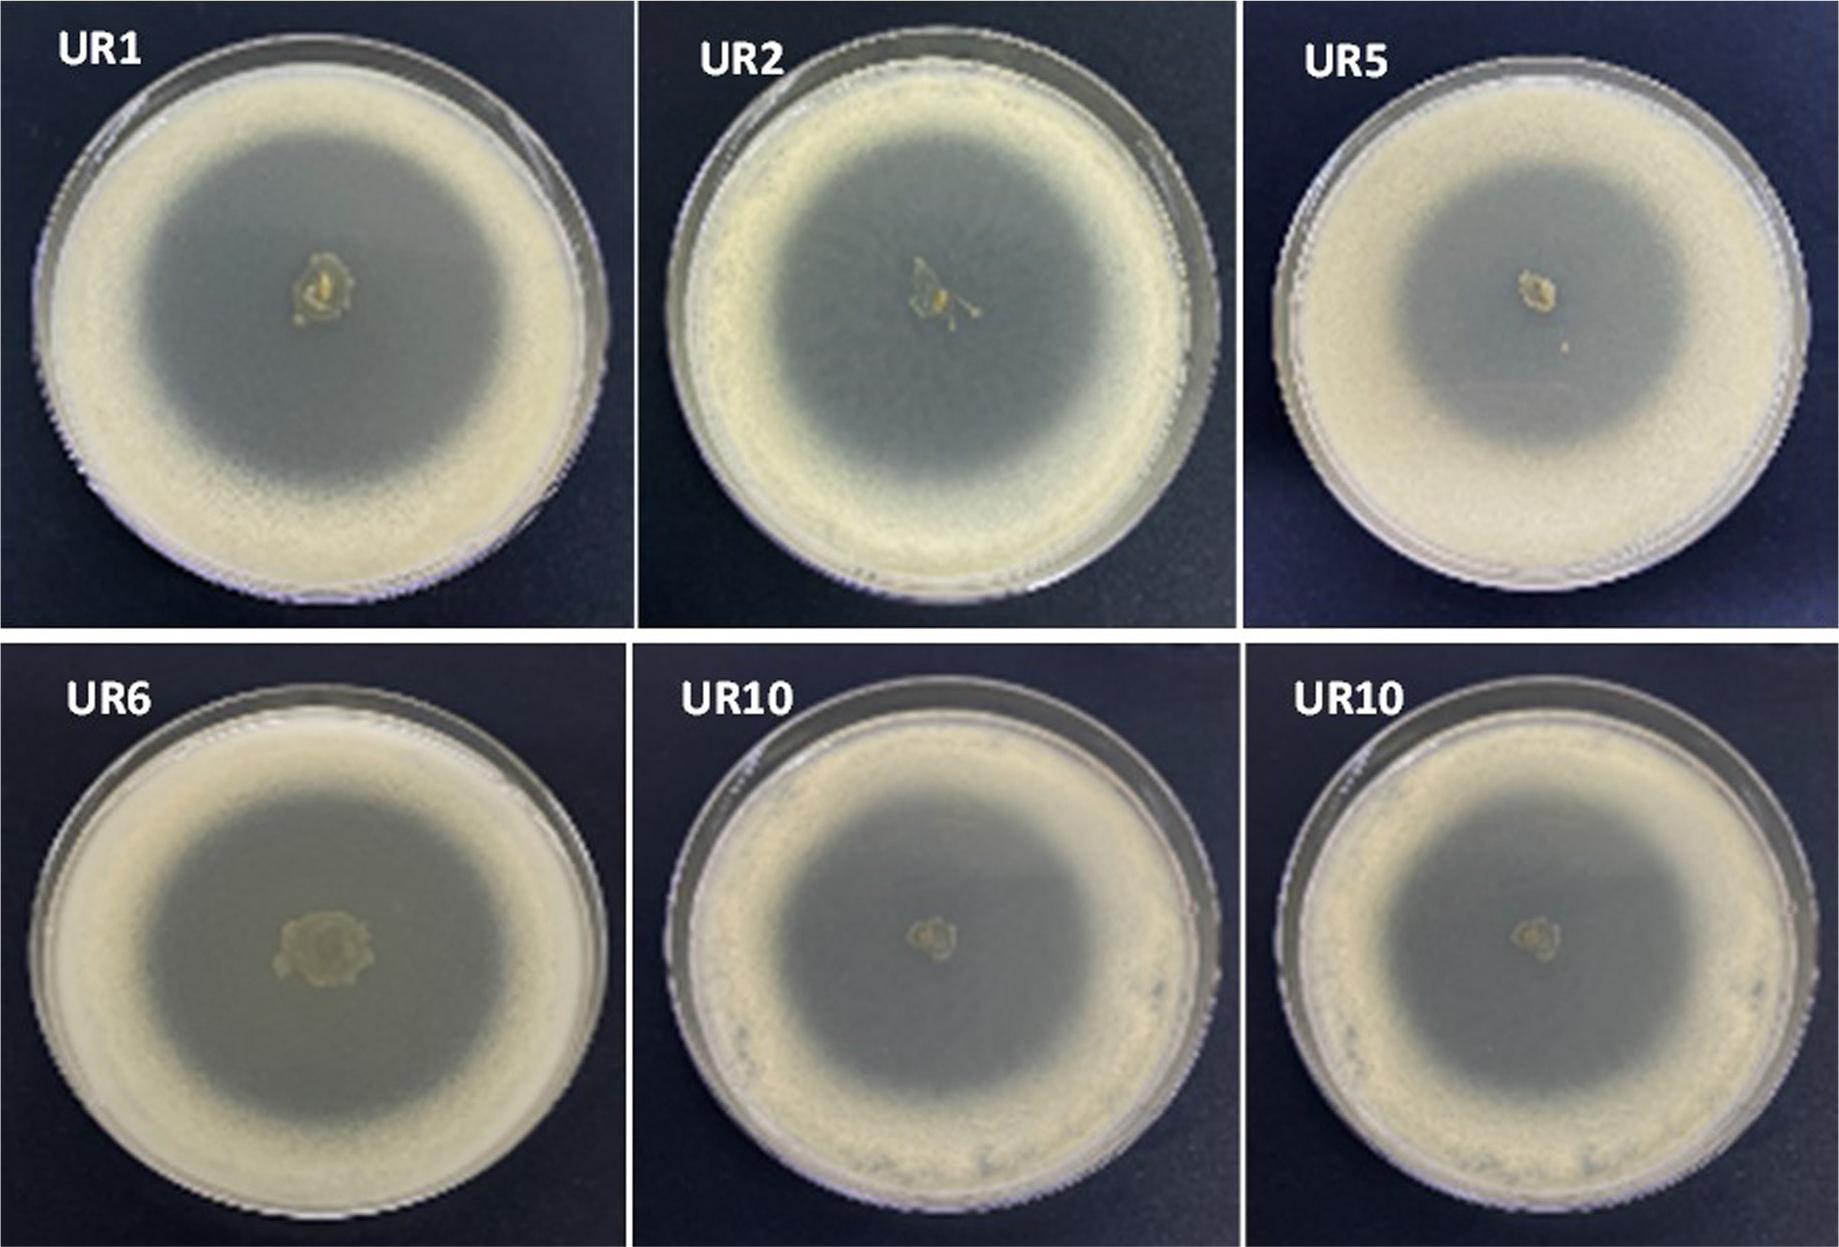

Uric acid (UA) is well known to prevent nervous system diseases and its lower level contributes to various autoimmune diseases such as lichen planes, Parkinson’s disease, and pemphigus vulgaris (Bakhtiari et al. 2017). Humans’ metabolism of purine derivatives yields uric acid as the end product. Metagenes in the gene coding sequence prematurely terminate the translation process, leading to the absence of uricase in humans. Excessive uric acid production could cause gout, kidney disorder, and hyperuricemia. Direct injection of urate oxidase is suggested to counter gout-linked renal complications and prevent chemotherapy-associated hyperuricemia disorders. Thus, uricase is a promising enzyme with clinical applications. High protein intake or reduced uric acid excretion via the kidneys increases blood uric acid levels (Xu et al. 2017; Bobulescu and Moe 2012). High uric acid levels damage kidneys’ surface cells and weaken their physiological activity, leading to chronic kidney diseases, particularly in Type-II diabetic patients (Kim et al. 2015; Xiao et al. 2015). Uric acid accumulation in the kidneys is the most common cause of kidney stones (Fathallah-Shaykh and Cramer 2014; Jalal 2016). A high level of uric acid also stimulates autacoids and hormones’ growth leading to high blood pressure. The infiltration of uric acid into smooth muscles weakness the heart muscle causing various cardiovascular diseases (Kanbay et al. 2013). High uric acid levels also complicate the refractory gout treatment. The peroxisomal (oxidoreductase) uricase enzyme catalyzes the purine ring’s oxidative opening in the urate pathway to generate allantoin, hydrogen peroxide, and carbon dioxide (Chaudhary et al. 2013; El Ridi et al. 2017). Uricase is used as a protein drug to reduce the accumulation of toxic urate and treat hyperuricemia, gout, and bedwetting. Recent studies have used uricase as a diagnostic reagent in biochemical diagnosis and as a sensitive, accurate biosensor to monitor uric acid levels in the urine and blood (Hafez et al. 2017; Cheung et al. 2020; Tandon et al. 2021). Uricase also serves as an additive in hair coloring agents’ commercial formulations, and in various medical, industrial, and agricultural applications (Elbanna et al. 2024). Diverse applicability has significantly enhanced the demand for this therapeutic enzyme.
Several organisms (microbes, animals, and plants) are known for uricase production (Elbanna et al. 2024). However, microbes offer cost-effective bioprocessing, convenient optimization of the medium, and higher growth rates. Green and Mitchell isolated the first microbial uricase in 1957 from the fungus Neurospora crassa (Perez-Ruiz et al. 2014). Then, multiple researchers isolated it from different bacteria such as Nocardia farcinica, Pseudomonas aeruginosa, Microbacterium spp., Bacillus thermocatenulatus, Bacillus fastidious, Arthrobacter globiformis, and Bacillus subtilis (Saeed et al. 2004; Suzuki et al. 2004; Zhou et al. 2005; Lotfy 2008;). Uricase production is extracellular in B. subtilis, P. aeruginosa, and B. thermocatenulatus whereas it is intercellular in Microbacterium spp., Proteus vulgaris, Streptomyces exofolitus, Streptomyces graminofaciens, and Streptomyces albidoflavus (Zhou et al. 2005; Aly et al. 2013). Lactic acid bacteria (Pediococcus spp., Leuconostoc spp., Bifidobacterium spp., Lactobacillus spp., and Enterococcus spp.) are known to degrade uric acid and their administration in rats effectively suppressed serum uric acid levels (Ogawa 2006). Alcaligenes faecalis could synthesize high uricase levels. This bacteria flourishes in birds and poultry intestines, soil, water, hospitals, and moist environments. Despite its presence in diabetic ulcers, it is non-pathogenic to humans (Simmons et al. 1979; Versalovic 2011; Abo-Amer et al. 2015).
Multiple factors could affect uricase enzyme activity. Previous studies have reported an optimum pH of 8 for uricase activity within a thermal range of 25–45°C. Uricase exposure to 60°C for an hour could reduce its activity by 50% (Chohan and Becker 2009; Ravichandran et al. 2015). Heavy metals are established cofactors for specific enzymes, but their higher concentration could inhibit enzyme activity (Suzuki et al. 2004). Copper inhibited uricase activity, which contradicts the findings of Ravichandran et al. (2015), who reported a copper-based enzyme stimulation by 140%. Similarly, EDTA (1M) based enzyme stimulation has also been reported in various studies (Chohan and Becker 2009; Ravichandran et al. 2015). Nitrogen and carbon sources in the fermentation media are crucial for the uricase-producing microorganisms’ growth and uricase productivity. Uricase production with different carbon sources has been reported whereas peptone is known to facilitate the highest uricase production among various other nitrogen sources (Pfrimer et al. 2010). Most published microbial uricase enzymes are intracellular, requiring cellular disruption to yield uricase. The production of extracellular enzymes is crucial for reducing the time and effort during the purification process (Elbanna et al. 2024).
Most uricase production-related studies focus on labor-intensive and expensive intracellular purification methods. Alcaligenes spp. It inhabits diverse types of environments; however, its extracellular uricaseproducing potential remains unexplored. This study highlights the significantly higher uricase synthesizing potential of Alcaligenes spp. Strain UR1 as compared to previous reports from other microbes. The findings of this study could help devise large-scale economic uricase production systems. The study further elaborates on optimized uricase production parameters for its improved applications. Thus, the study collectively involves isolating, identifying, and characterizing a novel uricase-producing bacterial strain and analyzing its industrial and therapeutic potential.
Different types of environmental samples from the cities of Makkah and Taif, Saudi Arabia, were used to isolate uricaseproducing bacteria. Samples comprised 20 pigeon and 20 chicken fecal droppings, which were collected from the pigeon and poultry farmers. Samples also included 10 agricultural soils, which were collected at a depth of 10–15 cm after removing the surface layer. An ice box was used to transfer the collected samples to the laboratory. High urea levels in chicken fecal droppings and urea-added agricultural soils make them a reliable source for isolating uricase-producing bacteria.
A uric acid enrichment broth medium [uric acid (8 g/l), KH2PO4(0.5 g/l), K2HPO4 (2 g/l), NaCl (0.1 g/l), MnSO4 · H2O (0.1 g/l), and CaCl2 (0.1 g/l)] was prepared with an initial pH of 7.4 followed by sterilization for 15 min at 121°C to enrich uric acid-degrading bacterial cultures (Ghosh and Sarkar 2014). Diluted samples (5 ml) were inoculated in the uric acid enrichment broth medium followed by incubation (48 h and 37°C) under shaking conditions. To isolate uricase-degrading bacteria, serial dilutions of enrichment cultures were transferred into the Petri dishes followed by the pouring of basal trace agar medium [uric acid (3 g/l), KH2PO4 (0.5 g/l), K2HPO4 (2 g/l), NaCl (0.1 g/l), MnSO4 · H2O (0.1 g/l), CaCl2 (0.1 g/l), FeSO4 · 7H2O (2.5 g/l), CuSO4 (2.5 g/l), and agar (15 g/l) at pH 7.2] (Ghosh and Sarkar 2014). The inoculated plates were incubated for 48 h at 37°C. Uric acid-degrading bacterial colonies appearing with clear zones were inoculated in new uric acid agar plates [uric acid (8 g/l), KH2PO4(0.5 g/l), K2HPO4 (2 g/l), NaCl (0.1 g/l), MnSO4 · H2O (0.1 g/l), and CaCl2 (0.1 g/l), and agar (15 g/l)]. The clear zone-forming isolates were sub-cultured multiple times in nutrient agar (NA) (HiMedia Laboratories Pvt. Ltd., India) and microscopic examinations were performed to confirm their purity. These isolates were coded with a “UR” and kept at 4°C as slant cultures.
Uricase-producing strains were streaked onto nutrient agar (NA) plates and incubated for 24 h at 37°C. After the purity check, the strains were inoculated in Nutrient broth (NB) (HiMedia Laboratories Pvt. Ltd., India) for 24 h at 37°C. Then, 500 μl of sterile glycerol was added to the 500 μl of each culture to make a final concentration of 20% and 7.5% (v/v), respectively. The tubes were stored at –80°C until further use. Culture purity was regularly confirmed through microscopic examinations, and single colonies were obtained by streaking on NA.
Uric acid agar was used to test the uricase activity of all isolates, which were then partially characterized based on the Gram staining, cell morphology, motility, and sporulation. The most promising uricase-producing isolates were selected based on the uricase activity and subjected to phenotypic and genotypic characterizations. The method of Gerhardt et al. (1994) was adopted for the phenotypic characterization. API 20E test kit (bioMérieux, France) was utilized for further biochemical and sugar fermentation tests, whereas more biochemical tests were performed using the Vitek® 2 compact system (bioMérieux, France) (Yang et al. 2012). Nutrient broth medium was used to study the differential growth at varying pH (pH 4–9), temperatures (20–45°C), and salt concentrations (0–9% NaCl), and a UV-VIS spectrophotometer (JASCO V-530; JASCO International Co., LTD., Japan) was employed to monitor bacterial growth at 650 nm.
The procedure of Abdalrahim et al. (2019), was followed to perform the hemolytic activity test. Briefly, the bacterial cultures of selected uricase-producing strains were spotted on sheep blood agar plates (Saudi Prepared Laboratory Media – SPLM-Riyadh, Saudi Arabia) that were incubated for 24 h at 37°C. The antibiotic susceptibility profiling of the selected uricaseproducing strains was conducted as well employing the Kirby-Bauer disk diffusion method (Bauer et al. 1966) according to the guidelines of Clinical and Laboratory Standards Institute (CLSI 2024), briefly, a 0.5 McFarland standard suspension was prepared from each isolate and spread onto Mueller-Hinton agar (HiMedia Laboratories Pvt. Ltd., India) plates and incubated at 37°C for 18–24 h after placing the antibiotic disks. Antimicrobial susceptibility testing was performed against 12 antibiotics (Oxoid™, Thermo Fisher Scientific Inc., USA) as follows: Piperacillin (100 μg), Ceftazidime (30 μg), Cefepime (30 μg), Cefotaxime (30 μg), Ciprofloxacin (5 μg), Imipenem (10 μg), Gentamicin (10 μg), Amikacin (30 μg), Tetracycline (10 μg), Aztreonam (30 μg), Chloramphenicol (30 μg), and TrimethoprimSulfamethoxazole (1.25/23.75 μg).
Nutrient broth (HiMedia Laboratories Pvt. Ltd., India) medium (50 ml) was used to grow (24 h at 37°C) uricase-producing strains for genomic DNA isolation. The cultures were centrifuged (4,000 rpm, 20 min) and pellets were washed once with a TE-buffer. Genomic DNA isolation was performed by following the method of Elbanna et al. (2010). PCR amplification of the 16S rRNA gene was carried out using the universal eubacteria primers. Electrophoresis was performed to confirm the PCR products (~1,540 bp), which were further purified by using a PCR extraction kit (Macherey-Nagel GmbH & Co. KG, Germany). The purified PCR samples were sent to Macrogen, South Korea to sequence 16S rRNA fragments with an Applied Biosystems™ 3730x1 automated DNA sequencer (Thermo Fisher Scientific Inc., USA). Then, the Clustal-X tool was employed to align obtained sequences of selected and reference strains (retrieved from the NCBI database) (Thompson et al. 1997). Tree View was used to construct and display the phylogenetic tree (Page 1996). The neighbor-joining method with a 100 bootstrap value was adopted to prepare a phylogenetic tree of uricase-producing other closely related strains of genus Alcaligenes spp. (Saitou and Nei 1987). The E. coli strain ATCC® 35218™ (J01859.1) and B. subtilis strain ATCC® 21331™ (AB018487.1) served as the out-group.
The growth and uricase secretion of strain UR1 were assessed under various parameters, including pH (pH 5–9), temperature (20–50°C), carbon sources (maltose, glucose, dextrose, sucrose, cellulose, and fructose), and nitrogen sources (urea, beef extract, peptone, yeast extract, casein, (NH4)2SO4, and NaNO3). Uric acid medium (uric acid, 0.3% w/v) was added into an Erlenmeyer flask (250 ml) and inoculated with a preculture (10 ml) that was grown on the nutrient broth for 15 h (Ghosh and Sarkar 2014). Nutrient agar plates were used to count the viable cells of strain UR1 and to monitor its growth. In contrast, cell-free supernatant was used to measure the uricase-secretion activity at 293 nm spectrophotometrically.
The uricase enzyme was electrophonically purified from one liter of cell-free strain UR1 culture supernatant with diethylaminoethyl-cellulose (DEAE cellulose) followed by Sephadex G100 column chromatography. Briefly, strain UR1 was cultivated in Erlenmeyer flasks (250 ml) with 50 ml BT, and 0.3% uric acid as a sole carbon source. The flasks were incubated (48 h, 37°C) on a rotary shaker (180 rpm) followed by centrifugation (8,000 rpm). A rotary evaporator was used to concentrate one litter of cell-free culture supernatant to 100 ml, and uricase was precipitated by cooling with ammonium sulfate (60%). The resultant precipitate was dissolved in 5 ml Tris-HCl buffer (0.02 M, pH 7.5) and dialyzed overnight in the same buffer (2 l) in a dialysis tube to remove salts and ammonium sulphate traces. This concentrated, partially purified, and dialyzed cell-free supernatant was applied onto a Superdex-200 HR gel filtration column (Amersham Pharmacia Biotech, Germany) and equilibrated at pH 7.5 with 50 mM Tris-HCl buffer. The same buffer was used to elute uricase at a 2 ml/min flow rate and a fraction size of 1 ml. A UV spectrophotometer was used to analyze the purified enzyme’s activity at 293 nm. Fractions with higher uricase activity were further concentrated under vacuum and subjected to uricase enzyme assays (Saeed et al. 2004; Ram et al. 2015).
The clear zone method was followed to perform uricase enzyme assays. Briefly, purified uricase enzyme (50 μl) was transferred onto uric acid (0.3% w/v)-containing opaque agar plates and incubated for 24 h at 37°C. The presence of active uricase was depicted by the clear zone formation (mm).
The reaction mixture was comprised of uric acid solution (3.57 mM, 100 μl)-containing sodium borate buffer (20 mM, 2 ml) at pH 7.5. The crude enzyme (100 μl) was added to the mixture to initiate the reaction followed by incubation for 30 min at 37°C. A UV visible spectrophotometer was used to measure the absorbance at 293 nm whereas the reduction in uric acid concentration was measured from the difference between blank and test absorbance. One unit (U) of enzyme activity was defined as the amount of uricase required to convert 1 μmol of uric acid into allantoin/minute at pH 7.5 and 37°C, whereas the millimolar extinction coefficient of uric acid (έ) was considered as 12.6 mM−1 cm−1 at 293 nm (Adámek et al. 1989; Pustake et al. 2019) The following equation was used to calculate the enzyme activity:
ΔA – absorbance; B – total volume of reaction mixture; C – volume of enzyme; DF – dilution factor; extinction coefficient of uric acid at 293 nm = 12.5.
SDS-poly-acrylamide gel electrophoresis (SDS-PAGE) under denaturing conditions was performed to assess the uricase enzyme’s molecular weight. Discontinuous SDS-PAGE consisted of a stacking gel (4% (w/v), pH 6.8) and a separation gel (12% (w/v), pH 8.9) (Laemmli 1970) a mini gel chamber (8.5 × 7 cm; Biometra GmbH, Germany) was used for electrophoresis, and brilliant blue R 250 stained the protein.
Laemmli’s technique (Laemmli 1970) was adopted to determine protein concentration. The protein-dye complex of the Bradford reagent shifted the maximum dye absorption from 465 to 595 nm. A protein sample (cell-free supernatant) of 50 μl was added to the Bradford reagent (950 μl) and incubated at room temperature for 5 min. Then, the absorbance was spectrophotometrically (Ultraspec IIIR, Sweden) measured at 595 nm. A standard curve was generated using different BSA concentrations (6 μg to 200 μg).
The purified enzyme reaction mixture was incubated at different temperatures (10–70°C) to find the optimum temperature for uricase. Then, the tubes were cooled and uricase activity was spectrophotometrically measured at 293 nm. Uricase stability at different temperatures (4–100°C) was assessed by incubating purified uricase (10 μg) in Tris-HCl buffer (50 mM, pH 7.4) in a thermos-block for 24 h. Uricase residual activity was spectrophotometrically determined at 293 nm.
Different buffers (phosphate and Tris-HCl buffer) were used to incubate the purified enzyme mixture at various pH levels (4 to 9.0) and 40°C. Then, tubes were assayed for uricase activity.
Different concentrations (100–4,000 μg/ml) of substrate (uric acid) were applied to the reaction mixture at pH 7.4 and 40°C. Then, the mixture was assayed for uricase activity (Sarni et al. 2016).
Different concentrations (25, 50, 75, 100, 120, and 130 μl) of purified enzyme (0.2–1 U/ml) were added to the reaction mixture to find the optimum enzyme concentration. The reaction mixture was incubated (pH 7.4, 37°C), and assayed for uricase activity.
The effect of inhibitors on uricase activity was investigated by preparing a 500 μl mixture of the purified strain UR1 solution (pH 7.5) and 500 μl of inhibitors [EDTA (10 mM), mercaptoethanol (0.1%), and 2 mM of Ca2+, K+, Cu2+, Mg2+, Fe2+, Mn2+, Co2+, and Zn2+]. The mixture (1 ml) was initially incubated for 30 min at 40°C and then kept at room temperature. The residual uricase activity was spectrophotometrically measured at 293 nm and compared with untreated enzyme activity (Ravichandran et al. 2015).
A total of fifty-two uricase-producing bacteria were isolated from the collected samples. Poultry waste samples yielded forty-two uricase-producing isolates, whereas the remaining isolates came from the soil samples (Table I). Clear zone forming isolates were purified and characterized (Fig. 1). All these isolates appeared as Gram-negative motile, and non-sporeforming short rods, and catalase, and oxidase positive. They exhibited uricase activity through clear zone formations around their colonies (Table I, II, and Fig. 1). The most promising of these isolates (UR1, UR2, UR5 UR6, and UR10) were selected for further genotypic and phenotypic characterizations.
Uricase activity of the selected strains based on the clear zone formation around colonies on the uric acid-supplemented (0.3%) BT agar.
Screening and partial characterization of uricase-producing isolates.
| Isolate code | Source of strains | Motility | Sporulation | Gram test | Uricase activity (mm) | |
|---|---|---|---|---|---|---|
| Gram stain | KOH test | |||||
| UR1 | Soil | – | + | + | – | 75 |
| UR2 | Soil | – | + | + | – | 74 |
| UR3 | Poultry wastes | – | + | + | – | 73 |
| UR4 | Poultry wastes | – | + | + | – | 70 |
| UR5 | Poultry wastes | – | + | + | – | 70 |
| UR6 | Soil | – | + | + | – | 70 |
| UR7 | Soil | – | + | + | – | 70 |
| UR8 | Poultry wastes | – | + | + | – | 70 |
| UR9 | Poultry wastes | – | + | + | – | 70 |
| UR10 | Poultry wastes | – | + | + | – | 70 |
| UR11 | Poultry wastes | – | + | + | – | 70 |
| UR12 | Poultry wastes | – | + | + | – | 70 |
| UR13 | Poultry wastes | – | + | + | – | 68 |
| UR14 | Poultry wastes | – | + | + | – | 68 |
| UR15 | Soil | – | + | + | – | 67 |
| UR16 | Poultry wastes | – | + | + | – | 66 |
| UR17 | Poultry wastes | – | + | + | – | 65 |
| UR18 | Poultry wastes | – | + | + | – | 65 |
| UR19 | Poultry wastes | – | + | + | – | 65 |
| UR20 | Poultry wastes | – | + | + | – | 65 |
| UR21 | Poultry wastes | – | + | + | – | 65 |
| UR22 | Poultry wastes | – | + | + | – | 65 |
| UR23 | Poultry wastes | – | + | + | – | 65 |
| UR24 | Soil | – | + | + | – | 62 |
| UR25 | Poultry wastes | – | + | + | – | 60 |
| UR26 | Poultry wastes | – | + | + | – | 60 |
| UR27 | Poultry wastes | – | + | + | – | 60 |
| UR28 | Soil | – | + | + | – | 60 |
| UR29 | Poultry wastes | – | + | + | – | 60 |
| UR30 | Poultry wastes | – | + | + | – | 60 |
| UR31 | Poultry wastes | – | + | + | – | 60 |
| UR32 | Poultry wastes | – | + | + | – | 60 |
| UR33 | Poultry wastes | – | + | + | – | 60 |
| UR34 | Poultry wastes | – | + | + | – | 60 |
| UR35 | Poultry wastes | – | + | + | – | 60 |
| UR36 | Poultry wastes | – | + | + | – | 60 |
| UR37 | Poultry wastes | – | + | + | – | 60 |
| UR38 | Poultry wastes | – | + | + | – | 55 |
| UR39 | Poultry wastes | – | + | + | – | 55 |
| UR40 | Poultry wastes | – | + | + | – | 55 |
| UR41 | Poultry wastes | – | + | + | – | 55 |
| UR42 | Poultry wastes | – | + | + | – | 55 |
| UR43 | Poultry wastes | – | + | + | – | 50 |
| UR44 | Poultry wastes | – | + | + | – | 50 |
| UR45 | Poultry wastes | – | + | + | – | 50 |
| UR46 | Poultry wastes | – | + | + | – | 50 |
| UR47 | Poultry wastes | – | + | + | – | 50 |
| UR48 | Poultry wastes | – | + | + | – | 45 |
| UR49 | Soil | – | + | + | – | 45 |
| UR50 | Poultry wastes | – | + | + | – | 45 |
| UR51 | Soil | – | + | + | – | 40 |
| UR52 | Soil | – | + | + | – | 40 |
Uric acid degrading bacteria were enriched in uric acid-supplemented (0.8%) enrichment broth followed by incubation for 48 h at 37°C under shaking conditions. Uric acid turbidity gradually disappeared during fermentation. Then, dilutions of enrichment cultures were inoculated on uric acid-supplemented (0.3%) BT agar plates where all the isolates formed clear zones.
Morphological and partial characterization of uricase-producing isolates.
| Characteristics | Most promising uricase-producing isolates | ||||
|---|---|---|---|---|---|
| UR1 | UR2 | UR5 | UR6 | UR10 | |
| Colony morphology: | |||||
| Form | Irregular | Irregular | Irregular | Irregular | Irregular |
| Color on NA | whitish | Whitish | Whitish | Whitish | Whitish |
| Pigment | – | – | – | – | – |
| Elevation | Flat | Flat | Flat | Flat | Flat |
| Opacity | Opaque | Opaque | Opaque | Opaque | Opaque |
| Consistency | Dry | Dry | Dry | Dry | Dry |
| Cell morphology: | |||||
| Shape | Rods shaped | Rods shaped | Rods shaped | Rods shaped | Rods shaped |
| Gram stain | – | – | – | – | – |
| Catalase | + | + | + | + | + |
| Oxidase | + | + | + | + | + |
| Sporulation | + | + | + | + | + |
| Motility | + | + | + | + | + |
| Carbon source utilization: | |||||
| Maltose | +\– | + | + | + | + |
| Dextrose | + | + | + | + | + |
| Fructose | + | + | + | + | + |
| D-Glucose | + | + | + | + | + |
| Sucrose | + | + | + | + | + |
| Nitrogen source utilization: | |||||
| Casein | + | + | + | + | + |
| Yeast extract | + | + | + | + | + |
| Urea | + | + | + | + | + |
| Growth on NaCl (%): | |||||
| 0 | + | + | + | + | + |
| 1% | + | + | + | + | + |
| 2% | +\– | +\– | +\– | +\– | +\– |
| 5% | – | +\– | +\– | +\– | +\– |
| 10% | – | – | – | – | – |
| pH optimum: | |||||
| 5 | + | +\– | +\– | +\– | +\– |
| 6 | + | +\– | +\– | +\– | +\– |
| 7 | + | + | + | + | + |
| 8 | + | + | + | + | + |
| 9 | +\– | +\– | +\– | +\– | +\– |
| Temperature optimum: | |||||
| 20°C | +\– | +\– | – | +\– | +\– |
| 30°C | + | + | + | + | + |
| 37°C | + | + | + | + | + |
| 40°C | + | + | + | + | + |
| 50°C | – | – | – | – | – |
| MacConkey agar: | – | – | – | – | – |
| Blood agar hemolysis | α-hemolytic | α-hemolytic | α-hemolytic | α-hemolytic | α-hemolytic |
| Enzyme secretion: | |||||
| Uricase | + | + | + | + | + |
| Urease | + | + | + | + | + |
| Protease | – | – | – | – | – |
| Amylase | – | – | – | – | – |
| Lipase | – | – | – | – | – |
| Cellulose | + | + | + | + | + |
+ – good growth; – – no growth; +/– – weak growth
The selected strains’ morphological, physiological, and biochemical activities were monitored under similar conditions to obtain comparable results (Table I–III). The colonies of strains UR1, UR2, UR5 UR6, and UR10 appeared whitish opaque, non-pigmented, and irregular on nutrient agar. The cell dimensions of strains UR1, UR2, UR5, UR6, and UR10 were observed as 2.02 × 0.63 μm, 2.51 × 0.70 μm, 1.86 × 0.67 μm, 2.99 × 0.53 μm, and 1.83 × 0.53 μm, respectively. These isolates were negative for protease, amylase, and lipase and positive for cellulase and uricase (Table II). They could grow at a wide range of temperatures (20–45°C) and pH (5–9), whereas optimum pH and temperature were noted as 7 and 37°C, respectively. These isolates tolerated a range of NaCl (0-2%), but weak growth was observed with more than 3% NaCl. Moreover, these non-lactose fermenters exhibited a hemolysis on blood agar (Table II).
API-20E profile of sugar fermentation and enzyme activity of uricase-producing isolates.
| Biochemical test | Uricase-producing isolates | Reference strain | |||||
|---|---|---|---|---|---|---|---|
| UR1 | UR2 | UR5 | UR6 | UR10 | Alcaligenes faecalis DSM13644 | ||
| 1 | O-nitrophenyl-b D-galactopyranoside (ONPG) | – | – | – | – | – | – |
| 2 | Arginine dihydrolase (ADH) | – | – | – | – | – | – |
| 3 | Lysine decarboxylase (LDC) | – | – | – | – | – | – |
| 4 | Ornithine decarboxylase (ODC) | – | – | – | – | – | – |
| 5 | Citrate (CIT) | + | + | + | + | + | + |
| 6 | Hydrogen sulfide (H2S) | – | – | – | – | – | + |
| 7 | Urease (URA) | + | + | + | + | + | – |
| 8 | Tryptophan deaminase (TDA) | – | – | – | – | – | + |
| 9 | Indole (IND) | – | – | – | – | – | + |
| 10 | Voges-Proskauer test (VP) | + | – | + | + | + | + |
| 11 | Gelatinase (GEL) | – | – | – | – | – | – |
| Sugar fermentation: | |||||||
| 12 | Glucose (GLU) | + | + | + | + | + | + |
| 13 | Mannose (MAN) | – | – | – | – | – | – |
| 14 | Inositol (INO) | – | – | – | – | – | – |
| 15 | Sorbitol (SOR) | – | – | – | – | – | – |
| 16 | Rhamnose (RHA) | – | – | – | – | – | – |
| 17 | Sucrose (SAC) | + | + | + | + | + | + |
| 18 | Melibiose (MEL) | – | – | – | – | – | – |
| 19 | Amygdalin (AMY) | – | – | – | – | – | – |
| 20 | Arabinose (ARA) | – | – | – | – | – | – |
+ – good growth, – no growth, +/– weak growth
+ – positive enzyme reaction, – negative enzyme reaction
Biochemical features and analytical profile index 20E (API 20E kit) revealed that the selected uricaseproducing strains were negative to O-nitrophenyl-b D-galactopyranoside (ONPG), tryptophan deaminase (TDA), arginine dihydrolase (ADH), hydrogen sulfide, lysine decarboxylase (LDC), gelatinase (GEL), indole (IND), and ornithine decarboxylase (ODC), but remained positive to Voges-Proskauer test (VP), citrate (CIT), and urease (URA). Uricase-producing strains demonstrated a narrow growth range on sugar fermentation. They utilized glucose (GLU), fructose, sucrose (SAC), dextrose, and maltose. However, they were unable to ferment rhamnose (RHA), mannose (MAN), sorbitol (SOR), inositol (INO), arabinose (ARA), melibiose (MEL), and amygdalin (AMY) (Table III).
The pattern of biochemical reactions in the bio-Mérieux Vitek® 2 compact system database depicted that uricase-producing isolates were positive to biochemical reactions such as L-lactate alkalinization (ILATk), D-glucose (dGLU), urease (URE), L-proline arylamidase (ProA), and tyrosine arylamidase (TyrA). Contrarily, they were negative to a wide range of biochemical reactions such as L-pyrrolydonyl-arylamidase (PyrA), Ala-Phe-Pro-arylamidase (APPA), D-cellobiose (dCEL), adonitol (ADO), L-arabitol (lARL), β-galactosidase (BGAL), Glutamyl arylamidase pNA (AGLTp), and other biochemical traits as shown in Table IV. Moreover, most of the selected strains showed resistance to Cefepime, Amikacin, and Aztreonam, however, they were sensitive to Tetracycline, Gentamicin, Chloramphenicol, and Imipenem. Strain UR1 was also resistant to Ceftazidime, Amikacin, and Aztreonam, but it was found to be sensitive to Trimethoprim, Gentamicin, Piperacillin, Tetracycline, Imipenem, Ciprofloxacin, Chloramphenicol, Cefotaxime, and Cefepime (Table V).
bioMérieux VITEK®-based biochemical tests of uricase-producing isolates.
| Carbon source utilization, enzymatic activities and resistance | Conc. (mg) | Uricase isolates/identification results | |||||
|---|---|---|---|---|---|---|---|
| UR1 | UR2 | UR5 | UR6 | UR10 | |||
| 1 | Ala-Phe-Pro-arylamidase (APPA) | 0.0384 | – | – | – | – | – |
| 2 | Adonitol (ADO) | 0.1875 | – | – | – | – | – |
| 3 | L-Pyrrolydonyl-arylamidase (PyrA) | 0.018 | – | – | – | – | – |
| 4 | L-Arabitol (lARL) | 0.3 | – | – | – | – | – |
| 5 | D-Cellobiose (dCEL) | 0.3 | – | – | – | – | – |
| 6 | β-Galactosidase (BGAL) | 0.036 | – | – | – | – | – |
| 7 | Production (H2S) | 0.0024 | – | – | – | – | – |
| 8 | β-N-acetyl-glucosaminidase (BNAG) | 0.0408 | – | – | – | – | – |
| 9 | Glutamyl arylamidase pNA (AGLTp) | 0.0324 | – | – | – | – | – |
| 10 | D-Glucose (dGLU) | 0.3 | + | + | + | + | + |
| 11 | γ-Glutamyl-transferase (GGT) | 0.0228 | – | – | – | – | – |
| 12 | Fermentation/glucose (OFF) | 0.45 | + | + | + | + | + |
| 13 | β-Glucosidase (BGLU) | 0.036 | – | – | – | – | – |
| 14 | D-Maltose (dMAL) | 0.3 | – | – | – | – | – |
| 15 | D-Mannitol (dMAN) | 0.1875 | – | – | – | – | – |
| 16 | D-Mannose (dMNE) | 0.3 | – | – | – | – | – |
| 17 | β-Xylosidase (BXYL) | 0.0324 | – | – | – | – | – |
| 18 | β-Alanine arylamidase pNA (BAlap) | 0.0174 | – | – | – | – | – |
| 19 | L-Proline arylamidase (ProA) | 0.0234 | + | + | + | + | + |
| 20 | Lipase (LIP) | 0.0192 | – | – | – | – | – |
| 21 | Palationse (PLE) | 0.3 | – | – | – | – | – |
| 22 | Tyrosine arylamidase (TyrA) | 0.0276 | + | + | + | + | + |
| 23 | Urease (URE) | 0.15 | + | + | – | + | + |
| 24 | D-Sorbitol (dSOR) | 0.1875 | – | – | – | – | – |
| 25 | Saccharose/sucrose (SAC) | 0.3 | – | – | – | – | – |
| 26 | D-Tagatose (dTAG) | 0.3 | – | – | – | – | – |
| 27 | D-Trehalose (dTRE) | 0.3 | – | – | – | – | – |
| 28 | Citrate (sodium) (CIT) | 0.054 | – | – | + | – | – |
| 29 | Malonate (MNT) | 0.15 | – | – | + | – | – |
| 30 | 5-Keto-D-gluconate (5KG) | 0.3 | – | – | – | – | – |
| 31 | L-Lactate alkalinisation (ILATk) | 0.15 | + | + | + | + | + |
| 32 | α-Glucosidase (AGLU) | 0.036 | – | – | – | – | – |
| 33 | Succinate alkalinisation (SUCT) | 0.15 | – | – | + | + | – |
| 34 | β-N-acetyl-galactosaminidase (NAGA) | 0.0306 | – | – | – | – | – |
| 35 | α-Galactosidase (AGAL) | 0.036 | – | – | – | – | – |
| 36 | Phosphatase (PHOS) | 0.0504 | – | – | – | – | – |
| 37 | Glycine arylamidase (GlyA) | 0.012 | – | – | – | – | – |
| 38 | Ornithine decarboxylase (ODC) | 0.3 | – | – | – | – | – |
| 39 | Lysine decarboxylase (LDC) | 0.15 | – | – | – | – | – |
| 40 | L-Histidine assimilation (IHISa) | 0.087 | -\+ | – | – | + | +\- |
| 41 | Coumarate (CMT) | 0.126 | + | – | – | – | – |
| 42 | β-Glucoronidase (BGUR) | 0.0378 | – | – | – | – | – |
| 43 | O/129 Resistance (comp.vibrio.) (O129R) | 0.0105 | – | – | – | – | – |
| 44 | Glu-Gly-Arg-arylamidase (GGAA) | 0.0576 | – | – | – | – | – |
| 45 | L-malate assimilation (IMLTa) | 0.042 | -\+ | +\- | + | – | – |
| 46 | Ellman (ELLM) | 0.03 | -\+ | -\+ | – | + | – |
| Identification and similarity according to VITEK® data base | Pseudomonas oleovorans (95%) | Pseudomonas oleovorans (95%) | Alcaligenes faecalis (97%) | Acinetobacter lwoffii (92%) | Acinetobacter lwoffii (96%) | ||
+ – good growth, – no growth, +/– weak growth; + – positive enzyme reaction, – negative enzyme reaction
Antibiotic susceptibility of uricase-producing promising isolates.
| Antibiotics | Antibiotics/Disc potency | Uricase-producing isolates | ||||
|---|---|---|---|---|---|---|
| UR1 | UR2 | UR5 | UR6 | UR10 | ||
| Amikacin | 30 μg (AK) | R | R | S | R | S |
| Gentamicin | 10 μg (GM) | S | S | S | S | R |
| Tetracycline | 30 μg (T) | S | S | S | S | S |
| Aztreonam | 30 μg (ATM) | R | R | R | R | R |
| Ciprofloxacin | 5 μg (CIP) | S | S | R | S | S |
| Cefotaxime | 30 μg (Cf) | S | S | R | R | R |
| Ceftazidime | 30 μg (CAZ) | S | R | S | R | S |
| Cefepime | 30 μg (CPM) | R | R | S | R | R |
| Imipenem | 10 μg (IMI) | S | S | S | S | S |
| Piperacillin | 100 μg (PRL) | S | S | R | R | S |
| Trimethoprim/sulfamethoxazole | 25 μg (TS) | S | S | R | S | R |
| Chloramphenicol | 30 μg (C) | S | S | S | S | S |
R – resistant; S – sensitive
bioMérieux Vitek® 2 compact system identification revealed the identity of strains UR1 and UR2 as Pseudomonas oleovorans with a 95% similarity. Strain UR5 exhibited 97% similarity with A. faecalis whereas strains UR6 and UR10 were identified as Acinetobacter lwoffii with a respective similarity of 92% and 96%. Due to the lower identity ratio of the Vitek 2 compact system, the most promising uricaseproducing isolates were further subjected to 16S rRNA-based molecular identification.
PCR amplification and sequencing of 16S rRNA gene (~1,540 bp) was carried out by using a genomic DNA template to confirm the identification of selected uricase-producing strains. 16S rRNA gene sequences of selected strains were deposited in the National Center for Biotechnology Information (NCBI) nucleotide sequence database under the accession numbers NR113993.1 (UR1), NR137421.1 (UR2), NR157609.1 (UR5), NR113993.1 (UR6), and NR181952.1 (UR10). These sequences were compared with similar ones on the NCBI database using the BLAST tool (http://www.ncbi.nlm.nih.gov). ClustalX program was employed to construct a phylogenetic tree of these sequences by adopting a neighbor-joining and maximum composite likelihood model with a bootstrap value of 100. B. subtilis strain ATCC® 21331™ (AB018487.1) and E. coli strain ATCC® 35218™ (J01859.1) served as the outgroup (Fig. 2, Table VI). 16S rRNA gene sequences indicated a close relationship of strain UR10 with Alcaligenes ammonioxydans strain HO-1 (NR_180910.1) and A. faecalis strain NBRC 13111 (NR_113606.1) with similarities of 98.84% and 98.02%, respectively. Strains UR1, UR2, UR5, and UR6 showed higher similarity of 96.96%, 95.40%, 97.28%, and 98.77% to A. faecalis (NR_113606.1) and A. ammonioxydans (NR_180910.1) respectively. Based on the phenotypic and genotypic features, the selected uricase-producing strains were characterized as the members of the genus Alcaligenes spp.
16S rRNA gene sequence-based molecular identification of uricase-producing promising strains.
| Isolate code | Blast match | Gene Bank Accession No. | 16S rRNA Identity (%) |
|---|---|---|---|
| Strain UR1 (PP563675) | – Alcaligenes faecalis strain NBRC 13111 | – NR_113606.1 | 96.96 |
| – Alcaligenes ammonioxydans strain HO-1 | – NR_180910.1 | 96.86 | |
| – Alcaligenes aquatilis strain LMG 22996 | – NR_104977.1 | 96.54 | |
| – Alcaligenes endophyticus strain AER10 | – NR_156855.1 | 95.91 | |
| – Alcaligenes pakistanensis strain NCCP-650 | – NR_145932.1 | 95.58 | |
| Strain UR2 (PP563676) | – Alcaligenes faecalis strain NBRC 13111 | – NR_113606.1 | 95.40 |
| – Alcaligenes ammonioxydans strain HO-1 | – NR_180910.1 | 95.19 | |
| – Alcaligenes aquatilis strain LMG 22996 | – NR_156855.1 | 94.97 | |
| – Alcaligenes endophyticus strain AER10 | – NR_156855.1 | 95.15 | |
| – Alcaligenes pakistanensis strain NCCP-650 | – NR_145932.1 | 93.79 | |
| Strain UR5 (PP563677) | – Alcaligenes ammonioxydans strain HO-1 | – NR_180910.1 | 97.28 |
| – Alcaligenes faecalis strain NBRC 13111 | – NR_113606.1 | 97.20 | |
| – Alcaligenes aquatilis strain LMG 22996 | – NR_104977.1 | 96.89 | |
| – Alcaligenes pakistanensis strain NCCP-650 | – NR_145932.1 | 96.11 | |
| – Alcaligenes endophyticus strain AER10 | – NR_156855. | 95.96 | |
| Strain UR6 (PP563678) | – Alcaligenes ammonioxydans strain HO-1 16S | – NR_180910.1 | 98.77 |
| – Alcaligenes faecalis strain NBRC 13111 16S | – NR_113606.1 | 98.56 | |
| – Alcaligenes aquatilis strain LMG 22996 | – NR_104977.1 | 98.15 | |
| – Alcaligenes endophyticus strain AER10 | – NR_156855.1 | 98.15 | |
| – Alcaligenes pakistanensis strain NCCP-650 | – NR_145932.1 | 98.15 | |
| Strain UR10 (PP563679) | – Alcaligenes ammonioxydans strain HO-1 | – NR_180910.1 | 98.84 |
| – Alcaligenes faecalis strain NBRC 13111 | – NR_113606.1 | 98.02 | |
| – Alcaligenes aquatilis strain LMG 22996 | – NR_104977.1 | 97.73 | |
| – Alcaligenes pakistanensis strain NCCP-650 | – NR_145932.1 | 96.98 | |
| – Alcaligenes faecalis subsp. phenolicus | – NR_042830.1 | 95.87 |
Similarity of uricase-producing isolates and closely related strains of genus Alcaligenes spp.

Phylogenetic tree of uricase-producing isolates (shown in blue) and closely related strains of genus Alcaligenes. Bootstrap values out of 100 are mentioned at the nodes. Escherichia coli strain ATCC® 35218™ (J01859.1) and Bacillus subtilis strain: ATCC® 21331™ (AB018487.1) served as the out-group.
The growth conditions of the uricasesecreting strain UR1 were optimized by incubating for different time intervals (24, 48, 72, and 96 h) at different temperatures (20, 25, 30, 37, 40, 45, and 50°C), and initial pH levels (pH 5, 5.5, 6, 6.5, 7, 7.5 8, 8.5, and 9). The results revealed maximum UR1 growth (2.5 OD) and uricase activity (65 U/ml) after 50 h of incubation (Fig. 3). The data depicted a drastic decrease in the growth and uricase activity of strain UR1 at temperatures over 40°C whereas the maximum growth (2.5 OD) and uricase activity (67 U/ml) was observed at 37°C (Fig. 4). Similarly, an initial pH 7 yielded the maximum UR1 growth (3 OD) and uricase activity (80 U/ml) (Fig. 5).

Effect of incubation period on the growth (OD) and uricase secretion of strain UR1

Effect of temperature on the growth (OD) and uricase activity (U/ml) of strain UR1.

Effect of pH on the growth (OD) and uricase activity (U/ml) of strain UR1.
Different carbon sources (fructose, glucose, sucrose, cellulose, maltose, and dextrose) were examined for uricase secretion. Optical density was spectrophotometrically measured at 600 nm and 293 nm to monitor growth and uricase activity, respectively. The maximum activity of the control treatment (only containing 0.3% uric acid in BT) was considered 100% to calculate the relative activity of various nitrogen and carbon sources. Data revealed that only sucrose enhanced the uricase secretion from strain UR1 with a 10% activity. In contrast, other carbon sources such as glucose, maltose, dextrose, and cellulose caused a reduction in uricase secretion by 50, 40, 25, and 20%, respectively compared to the control (Fig. 6).

Impact of carbon and nitrogen sources on strain UR1 growth and uricase activity (U/ml).
Similarly, uric acid-supplemented (0.3% w/v) BT medium was individually supplemented with different nitrogen sources [yeast extract, beef extract, peptone, casein, urea (organic), (NH4)2 SO4 (inorganic), and NaNO3] at an initial pH 7. Optical density was spectrophotometrically measured at 600 nm and 293 nm to monitor growth and uricase activity, respectively. The results revealed that all organic nitrogen sources (e.g., yeast extract, beef extract, peptone, casein, and urea) enhanced the uricase secretion of strain UR1 by 12, 10, 8, and 7% as compared to the control treatment (100%). Inorganic nitrogen sources such as sodium nitrate, ammonium sulfate, and urea significantly inhibited the uricase secretion of strain UR1 by 80, 83, and 88% compared to control (Fig. 6).
The impact of salt was assessed by adding different NaCl concentrations (0.1, 0.2, 0.5, 1, 1.5, and 2%, w/v) in uric acid-containing BT medium at an initial pH 7. The results indicated a significant reduction in strain UR1 growth and uricase activity with the rise in salt concentration whereas the maximum growth (3 OD) and uricase secretion (80 U/ml) were observed at a NaCl concentration of 0.1% (Fig. 7).

Impact of different NaCl (%) concentrations on strain UR1 growth (OD) and uricase activity (U/ml).
DEAE sepharose-based uricase purification from strain UR1 remained unsuccessful. Therefore, the Gel filtration column (Sephadex G100 Column chromatography) was used for the protein purification, which was confirmed by measuring the absorption at 293 nm. Fractions of 5 ml to 12 ml were used to detect uricase activity (Fig. 8). SDS-PAGE was performed to check the purity of the fractions with high uricase activity (Fig. 9). Uricase purification by gel filtration chromatography yielded the fractions with purities of 66.37% (275 U/ml) and 19% (916 U/mg) (Table VII). Notably, the enzyme presented a very high uricase activity (275 U/ml) compared to the previous reports.

Uricase purification from strain UR1 by gel filtration. Uricase activity exhibiting fractions (F7-F12).
Gel-filtration-based uricase purification steps from strain UR1.
| Purification steps | Volume (ml) | Uricase activity (U/ml) | Total uricase activity (U) | Protein concentration (mg/ml) | Specific activity (U/mg) | Purification (fold) | Yield (%) |
|---|---|---|---|---|---|---|---|
| Crude enzyme (10 fold concentration) | 100 | 75 | 7,500 | 5.4 | 13.8 | 1 | 100 |
| Dialysis after ammonium sulfate precipitation | 5 | 112 | 560 | 3.8 | 29.74 | 2.13 | 7.40 |
| Gel filtration (Sephadex) | 5 | 275 | 1,375 | 0.3 | 916 | 66.73 | 18.33 |
SDS-PAGE revealed the homogeneity of purified uricase. The brilliant blue R-250 staining method was followed to visualize protein bands, which revealed a molecular mass of 45 kDa in a single polypeptide form (Fig. 9).

SDS-PAGE of the purified uricase from strain UR1.
SDS-denatured samples (20–40 μl) were separated in an SDS-polyacrylamide gel (12%) and stained with Serva blue R. Lane 1: molecular mass standard, Lane 2: protein (10 μg) of purified enzyme.
The data revealed maximum uricase activity at 40°C whereas uricase activity was not observed below 20°C and above 70°C (Fig. 10a). Uricase stability at different temperatures (0–100°C) was assessed through overnight incubation followed by the measurement of residual activity. The maximum activity was referred to as 100% relative activity. The enzyme was found to maintain its activity up to 50°C. The results depicted that enzyme activity was significantly reduced by 20, 60, and 95% at 60, 70, and 80°C, respectively, whereas a complete loss of activity was observed at 90°C (Fig. 10b).

Effect of temperature on a) uricase activity, and b) stability.
The activity of purified uricase was noted at a broad pH range (5–9) whereas the maximum activity (275 U/ml) was recorded at pH 7.5. It also retained 94, 80, and 20% activity at pH 8, 8.5, and 9, respectively. Alkaline pH above 9 resulted in a complete loss of enzyme activity. Similarly, only 6% activity was noted at pH 5.0 whereas enzyme activity was completely lost at pH 4 (Fig. 11).

Effect of pH on the uricase activity of strain UR1.
The enzyme activity gradually increased with the rising uric acid concentration, and maximum activity was observed at 2,000 μg. Then, it remained constant, indicating that the enzyme had already been filled/saturated with the substrate and achieved its optimal condition (Fig. 12).

Effect of substrate concentration on uricase activity of strain UR1.
The results indicated drastic inhibition in uricase activity of strain UR1 by β-mercaptoethanol (94.6%) followed by EDTA (66.8%), Co2+ (61.81%), and Zn2+ (31.20%). Contrarily, Ca2+ strongly enhanced the uricase activity (20%), whereas other metal ions such as Cu2+, Mg2+, and Mn2+ caused a slight increase of 6, 5, 3, and 2%, respectively (Fig. 13).

Effect of the metal ions and inhibitors on uricase activity of strain UR1.
This study isolated fifty-two uricase-producing bacteria from environmental samples (poultry fecal droppings and soil). Traditional laboratory protocols and the bioMérieux Vitek® 2 compact system were employed for these isolates’ biochemical and phenotypic characterization (Gerhardt et al. 1994). bioMérieux Vitek® 2 compact data identified strains UR1 and UR2 as P. oleovorans with a 95% similarity. Strain UR5, with a similarity of 97%, was identified as A. faecalis whereas strains UR6 and UR10 exhibited a 92% and 96% similarity with A. lwoffii. Due to the lower identity of the selected isolates by the Vitek® 2 compact system, these uricase-producing isolates were further subjected to 16S rRNA gene sequence-based molecular identification. Kim et al. (2017) also reported misidentification of four Alcaligenes spp. strains as A. faecalis by the Vitek® 2 compact system. Biochemical patterns showed a wide range of negative results, possibly due to the misidentification of four slow-growing A. baumannii clinical isolates by the Vitek® 2 compact system. The system could not differentiate A. baumanni from A. faecalis (Kim et al. 2018). Guo et al. (2014) also revealed two generic errors in Vitek® 2 compact system-based A. baumannii identification. Therefore, the results of the Vitek® 2 compact system should be carefully interpreted followed by the confirmation through 16S rRNA sequencing or MALDI-TOF methods, which provide rapid and precise bacterial identification in clinical laboratories.
Uricase-producing strains were further confirmed through PCR amplification and sequencing of 16S rRNA gene (~1,540 bp). The 16S rRNA gene sequences of selected isolates were compared with identical sequences on NCBI databases. Phylogenetic tree of the 16S rRNA gene sequences categorized uricase-producing strains in the genus Alcaligenes spp. (Castellani and Chalmers 1919) belonging to the Alcaligenaceae family under the Proteobacteria β subgroup. These results confirmed uricase production in various bacteria including genus Alcaligenes in addition to previously reported bacteria such as S. graminofaciens, P. aeruginosa, S. albidoflavus, Microbacterium, Bacillus cereus, P. vulgaris, B. thermocatenulatus, and Lactobacillus plantarum (Saeed et al. 2004; Azab et al. 2005; Zhou et al. 2005; Lotfy, 2008; Amirthanathan and Subramaniyan 2012).
The analysis of 16S rRNA gene sequences indicated a close relationship of strain UR10 with A. faecalis strain NBRC 13111 (NR_113606.1) and A. ammonioxydans strain HO-1 (NR_180910.1) with a similarity of 98.02% and 98.84%, respectively. Other strains (UR1, UR2, UR5, and UR6) clustered together in a new clade and exhibited similarity (96.96, 95.40, 97.28, and 98.77%) to A. ammonioxydans (NR_180910.1) and A. faecalis (NR_113606.1). Alcaligenes spp. is common in water and soil environments, and intestinal tracts of vertebrates (Ray and Pattnaik 2024). Conventional phenotypic bacterial identification is generally not as accurate as genotypic methods.
Therefore, comparing the 16S rRNA gene sequence has an established genetic identification method, which can efficiently identify phenotypically aberrant, poorly described, and rarely isolated strains (Clarridge 2004). Generally, this technique can differentiate organisms at the genus, species, and subspecies levels across major bacterial phyla. The rare limitation of this method could occur with highly similar sequences (Clarridge 2004). Prokaryotic species exhibit a minimum of 3% difference in the 16S rRNA sequence. Therefore, a bacterial species is referred to as a collection of strains with a higher overall similarity, which differs from related strain groups in multiple independent features (Madigan et al. 2000). The 16S rRNA gene is as a base for modern bacterial classification with a limited variation for closely related taxa (Fox et al. 1992). The members of the genus Alcaligenes are considered opportunistic human pathogens (Cruz et al. 2021). The Gram-negative genus Alcaligenes belongs to the Alcaligenaceae family under the order Burkholderiales. The type species A. faecalis further contains three subspecies (A. faecalis subsp. phenolicus, A. faecalis subsp. parafaecalis, A. faecalis subsp. faecalis), whereas the genus has three other species such as A. endophyticus, A. pakistanensis, and A. aquatilis (Mehanni and Abd El-Aziz 2019). The limitation of 16S rRNA sequence in differentiating closely related species could be overcome by DNA-DNA hybridization method by whole genome sequencing or housekeeping gene sequence (Murray et al. 1990). Therefore, further studies involving more advanced genetic and molecular techniques are needed to validate novel uricase-producing strains.
Uricase is found in almost all organisms (mammals, bacteria, yeasts, fungi, and plants except humans (Honarbakhsh et al. 2021). The uricase enzyme, predominantly found in the liver, forms a tetramer with each subunit weighing approximately 32–34 kDa, and this enzyme is associated with peroxisomes (Wu et al. 1989). Uricase synthesizes crystalloid core in hepatocytes’ peroxisomes and is well-known to treat gout arthritis. Higher uric acid levels in biological fluids (3.6 mg dl-L in children, 6 mg dl-L in females, and > 7 mg dl-L in males) cause hyperuricemia, which refers to monosodium urate crystal formation in the blood leading to inflammation and discomfort in and around joints (Nelapati et al. 2021). The lack of uricase also contributes to gout in humans and thus its administration is suggested to decrease uric acid levels in the plasma to treat gout and hyperuricemia (Nanda and JagadeeshBabu 2016). Initially, Aspergillus flavus-based uricase was used to treat gout, and tumor lysis-associated hyperuricemia. European and the United States Food and Drug Administration (US FDA) have approved a recombinant A. flavus uricase (Rasburicase, Elitek®, Sanofi-Aventis) and a PEGylated chimeric porcine-baboon uricase (Pegloticase, Krystexxa®, Savient Pharmaceuticals) to safely and rapidly reduce uric acid levels in plasma (Gabison et al. 2008) Rasburicase, a Saccharomyces cerevisiae polypeptide chain (301 amino acids), acts as an allopurinol alternative, and it controls uric acid levels more effectively than allopurinol (Zhu et al. 2022).
Higher uric acid levels in urine and blood raise the risk of neurological diseases, kidney illness, stroke, cardiovascular diseases, and hypertension. Childhood leukemia is also linked to higher urate content (Roopa et al. 2022). Metabolic diseases generating and forcing diuresis and urine alkalinization are treated through medication. Xanthine oxidase inhibitors (febuxostat and allopurinol) are often used to alleviate uric acid production. Frequent uricase administration induces anaphylaxis and allergic responses as it is primarily composed of foreign antigenic proteins. Allopurinol is commonly recommended for hyperuricemia treatment (Beedkar et al. 2012). Moreover, uricosuric medicines and recombinant uricase preparations are used to reduce uric acid concentrations (Pierzynowska et al. 2020).
An appropriate medium with optimized contents and parameters is crucial for cost-effective industrialscale enzyme production. Generally, the one factor at a time (OFAT) method is considered an effective approach for devising optimal medium components and parameters. OFAT has been adopted to optimize and increase uricase production in various strains, such as Halobacillus spp. strain GCFx14, Bacillus licheniformis, and B. subtilis strain SP6 (Pawar and Rathod, 2018; Honarbakhsh et al. 2021; Pustake et al. 2019; 2022). Thus, the OFAT approach can reveal effective nutrient sources to enhance extracellular enzyme production in the target bacterium. Several factors contribute to uricase production in bacteria. Thus, important factors such as production strain, temperature, incubation time, pH, salinity, fermentation media, and different carbon and nitrogen sources were investigated during this study. Out of the fifty-two uricase-producing strains, the most promising strain, UR1, producing the largest clear zone diameter in minimum time, was selected for further studies based on the uric acid plate assay. The OFAT approach was adopted to optimize the growth and uricase secretion of strain UR1.
During this study, the growth and uricase secretion of strain UR1 were optimized by evaluating different incubation times (24, 48, 72, and 96 h), temperatures (20, 25, 30, 37, 40, 45, and 50°C), and initial pH (pH 5, 5.5, 6, 6.5, 7, 7.5 8, 8.5, and 9). The results revealed that strain UR1 achieved maximum growth (2.5 OD) and uricase activity (65 U/ml) after 50 h incubation period. Initial growth phases were characterized by a high uric acid consumption rate, leading to reduced uric acid concentration and increased biomass. Ghosh and Sarkar (2014) have also reported 99% uric acid consumption by Comamonas spp. in 33 h at 37°C. Atty and Joseph (2016) reported a higher uric acid consumption rate by Ochrobactrum anthropic strain during initial growth phases, which reduced the uric acid concentration with an increase in biomass. Most strains consume more than 25% uric acid within 20 h of bacterial growth.
The data demonstrated a drastic reduction in strain UR1 growth and uricase activity at a temperature of more than 40°C whereas the maximum growth (2.5 OD) and uricase activity (67 U/ml) were observed at 37°C. The maximum strain UR1 growth (3 OD) and uricase activity (80 U/ml) were noted at an initial pH of 7.5. Jagathy et al. (2016) have also reported an optimum initial pH of 7 and an optimum temperature range of 30–37°C for growth and uricase secretion from B. subtilis. However, other studies have stated a lower optimum pH of 5.5 for uricase activity (Abdel-Fattah et al. 2005; Li et al. 2006).
Different nitrogen and carbon sources in the media play a pivotal role in the growth of uricase-producing microorganisms. The results revealed a sequence of various carbon sources’ efficiency as sucrose > glucose > cellulose > starch > maltose On the other hand, peptone appeared to be the most efficient nitrogen source for uricase production among different sources (Pfrimer et al. 2010). It seems that only sucrose was able to enhance uricase secretion of strain UR1 by 10%, whereas other carbon sources such as glucose, maltose, dextrose, and cellulose reduced uricase secretion by 50, 40, 25, and 20% as compared to control, which could be caused by glucose effect. These results align with the findings of Thillainayagi et al. (2021), who found that sucrose facilitated the maximum growth as a carbon source whereas uric acid favored the highest growth and uricase activity as the sole nitrogen source. Liu et al. (2023), also suggested the possibility of glucose-based suppression of uric acid metabolism. However, some glucose-containing media (BHI and GAM) support uric acid consumption. Watanabe and Morita (1973), also reported a glucose-linked inhibition of uricase formation in the absence of potassium ions. Recent reports have suggested the role of potassium ions in protein synthesis. It highlights an increased need for potassium ions in the presence of glucose in the medium. The impact of glucose on uricase formation is associated with glucose metabolism, which might depend on the presence of potassium ions. Glucose metabolism might produce an inhibitory metabolite without potassium ions to restrict enzyme formation. Jagathy et al. (2016), reported a decrease in enzyme productivity as sucrose > starch > glucose > citric acid > lactose. Handayani et al. (2018), also reported an inhibition in L. plantarum-based uricase production at high glucose concentrations. However, uricase synthesis in most microorganisms is regulated by growth medium components and their uric acid degrading capability. Moreover, metabolite (nitrogen or carbon origin)-based repression could also control uricase production in microorganisms (Van Der Drift et al. 1975; Bongaerts et al. 1977).
Yeast extract, casein, peptone, and beef promoted the uricase secretion of strain UR1 by 12, 10, 8, and 7% compared to control (100%). Contrarily, inorganic nitrogen sources such as urea, ammonium sulfate, and sodium nitrate significantly inhibited the uricase production of strain UR1 by 88, 83, and 80% as compared to control. Lotfy (2008) also noticed enhanced uricase production with various nitrogen sources such as corn steep liquor, maize milk, peptone, yeast extract, soybean, beef extract, and sodium glutamate. Amirthana than and Vijayakumar (2011) found yeast extract and sucrose as the best nitrogen sources for uricase production whereas inorganic nitrogen sources (potassium nitrate and ammonium sulfate) yielded the lowest values. Organic nitrogen sources might contain growth-promoting amino acids, which cells could metabolize directly to enhance uricase production (El-Naggar 2015; Lotfy, 2008; Pustake et al. 2019). Pustake et al. (2019) reported a significant impact of FeSO4 · 7H2O, lactose, and soya peptone on uricase production, whereas the effects of NaCl, MgSO4 · 7H2O, K2HPO4, and NH4NO3were non-significant.
Thillainayagi et al. (2021) stated that sucrose induced the maximum growth (2.1 OD) and uricase activity (36 U/ml/min) whereas fructose remained the most ineffective carbon source. Similarly, uric acid facilitated the highest uricase production (31 U/ml/min) and growth (1.83 OD), whereas potassium dihydrogen phosphate remained the least effective nitrogen source. In line with the current study, Atalla et al. (2010) noted uric acid and sucrose as the best nitrogen and carbon sources for Gliomastix gueg isolate-based uricase production. Zhou et al. (2005) demonstrated maize milk as the best nitrogen and carbon source for a Microbacterium spp. isolate. The findings of Nanda and Babu (2014) contradicted the current study as they reported sucrose as the less effective carbon source. Furthermore, they found asparagine as the best nitrogen source whereas ammonium nitrate and yeast extract supported a low uricase productivity in a B. cereus strain. Lekshmy and Raval (2016) isolated a Comamonas testosteroni strain from poultry waste that exhibited maximum uricase activity (0.15 U/ml) at pH 7 and 30°C with peptone and cellulose as the ideal nitrogen and carbon sources. Selvaraj and Thirumalai (2017) reported 35°C, pH 5, glucose (carbon source), and peptone (nitrogen source) as the optimum parameters for P. aeruginosa isolate growth and uricase production. Higher salt concentrations significantly impacted the UR1 growth whereas the lower NaCl (0.1%) concentration favored the maximum growth (3 OD) and uricase secretion (80 U/ml). These findings contradict the results of Atty and Joseph (2016) who achieved optimum O. anthropic growth at 0.5% NaCl concentration. Amirthanathan and Vijayakumar (2011) also noticed a salinity concentration of 1.5% optimum for P. aeruginosa growth and uricase secretion.
This study purified an extracellular uricase produced by strain UR1 from the culture supernatant without cell disruption, indicating uric acid’s key role in uricase production. Contrarily, most published microbial uricase enzymes are intracellular, requiring cell disruption for uricase secretion (Yokoyama et al. 1988; Zhou et al. 2005; Azab et al. 2005; Kai et al. 2008). DEAE-Sepharose-based uricase purification was not successful during this study. However, the addition of the gel filtration chromatography step yielded 66.37% and 18.33% pure uricase with 275 U/ml and 916 U/mg of volume and specific activity, respectively. Interestingly, this purified uricase from strain UR1 exhibited a very high uricase activity (275 U/ml) as compared to published uricase enzymes from S. graminofaciens (8 U/ml), A. globiformis (22 U/ml), Microbacterium spp. (1.0 U/ml), P. vulgaris (8.7 U/ml), P. aeruginosa (7.1 U/ml) and (40 U/ml), Comamonas spp. (80 U/ml), and B. thermocatenulatus (1.25 U/ml) (Kiba et al. 2000; Abdel-Fattah et al. 2005; Azab et al. 2005; Zhou et al. 2005; Khucharoenphaisan and Sinma 2011; Ghosh and Sarkar 2014; Amirthanathan and Vijayakumar 2011). Multiple studies purified uricase from P. aeruginosa strain’s culture filtrate in two steps involving ammonium sulfate (70%)-based precipitation saturation and ion exchange chromatography on DEAE-cellulose. The process purified 7.2 fold uricase with a yield of 43.79%. This method has been followed in various studies for the precipitation and partial purification of uricase enzymes from Gliomastix gueg, P. aeruginosa, Candida utilis, Streptomyces spp., Proteus spp., B. cereus using ammonium sulphate (60–80% w/v) (Adámek et al. 1989; Saeed et al. 2004; Azab et al. 2005; Atalla et al. 2010; Nanda et al. 2012).
This study used SDS-PAGE to evaluate purified uricase from strain UR1, which appeared as a single polypeptide of 45 kDa molecular mass. However, the molecular mass of purified uricase from different sources could be different. SDS-PAGE of purified enzymes from different microorganisms revealed varying molecular masses enzyme of 35 kDa from Comamonas spp. BT UA strain with a single protein band (Ghosh and Sarkar 2014) 33 kDa from P. aeruginosa (Amirthanathan and Vijayakumar 2011) 48 kDa from B. subtilis (Jagathy et al. 2016), 34 kDa from C. utilis (Koyama et al. 1996), and 60 kDa from B. subtilis (Pfrimer et al. 2010). Several factors, including pH and temperature, could affect uricase enzyme activity and stability. Different studies have reported an optimum pH of 8 and a temperature range of 25–45°C for better enzyme activity. The enzyme activity is often reported to decrease by 50% after exposure to 60°C for one hour (Chohan and Becker 2009; Ravichandran et al. 2015). This study demonstrated a maximum activity of purified uricase enzyme at 40°C that was sustained up to 50°C. However, the enzyme activity was completely lost at 90°C. Moreover, the purified uricase remained active within a broad range of pH (5–9) and exhibited the maximum activity (275 U/ml) at pH 7.5, which gradually decreased to 94, 80, and 20% at pH 8, 8.5, and 9, respectively. The activity was completely lost above pH 9. The enzyme activity was also not detected at pH 4.0 whereas only 6% of the relative activity was observed at pH 5. Thillainayagi et al. (2021) have also reported greater stability of crude enzyme from A. faecalis at a wide range of temperatures and pH as it retained more than 70% and 60% of residual activity, respectively. Zhou et al. (2005) reported enzyme stability at 37°C and pH 8.5 for more than 40 days whereas uricase remained stable with 100% activity even after heat treatment at 70°C for 30 min. Multiple studies reported stable uricase activity at pH 8–9 with peak enzyme activity and stability at pH 8.5 and 30°C (Kai et al. 2008; Nanda and Babu 2014). Jagathy et al. (2016) noticed a maximum activity of B. subtilis-yielded uricase at pH 7 whereas other studies reported a relatively lower pH of 5.5 as an optimum pH for uricase activity (Abdel-Fattah et al. 2005; Li et al. 2006). An optimum temperature range of 30°C to 35°C has been revealed in some studies for uricase production (Abdel Fattah et al. 2005).
Uricase activity was significantly reduced against various inhibitors such as β-mercaptoethanol (94.6%), EDTA (66.8%), Co2+ (61.81%), and Zn (31.20%). Ca2+ strongly promoted the uricase activity (20%) whereas the increase in uricase activity with other metal ions [Cu2+ (6%), Mg2+ (5%), and Mn2+ (2%)] was comparatively low. It suggests that metal ions could bind to the uricase enzyme to change the enzymatic activity through destabilization or stabilization of the enzyme’s conformation. EDTA-based uricase activity inhibition might be overcome by adding metal ions as cofactors. In this regard, several studies have reported varying effects of cations on enzyme stability and activity (Bakhtiar et al. 2003; Patel et al. 2006; Kai et al. 2008; Atalla et al. 2010; de Oliveira et al. 2010; Ravichandran et al. 2015).
The novelty of this study the enzyme volume and activity of uricase-producing strain of Alcaligenes spp. (UR1). Uricase enzyme exhibited significant specific activity of 916 U/mg and volume activity of 275 U/ml. These values are significantly higher than Microbacterium spp. (1 U/ml) and S. graminofaciens (8 U/ml). Moreover, extracellular uricase synthesis by strain UR1 distinguishes it from other bacteria (P. aeruginosa and B. subtilis), which are only capable of intracellular uricase production (Azab et al. 2005; Zhou et al. 2005). The extracellular uricase synthesis alleviates the processing cost and presents strain UR1 as an efficient tool for industrial applications.
This study aligns with previous investigations, highlighting the uricase enzyme’s industrial and therapeutic roles. Uricase efficacy has been established for the clinical treatments of hyperuricemia and gout. Similarly, Pegloticase and Rasburicase recombinant enzymes have already been approved for clinical applications (Gabison et al. 2008). However, the high cost of production and immunogenicity are major restrictions of these enzymes. Strain UR1-associated extracellular uricase enzyme’s higher stability and activity offer an economical alternative to avoid these hurdles. During this study, sucrose served as the carbon source, considerably improving uricase synthesis and activity. Contrarily, glucose restricted the uricase synthesis, which aligns with previous reports (Watanabe and Morita 1973). Organic nitrogen sources (yeast extract and peptone) also improved enzyme growth and yield whereas inorganic nitrogen sources restricted enzyme synthesis. These findings agree with previous studies and provide valuable information regarding fermentation media optimization during uricase synthesis (Lotfy 2008; Thillainayagi et al. 2021).
The findings of this study offer effective therapeutic and industrial applications.
Highly stable and active uricase enzyme from strain UR1 can be used as an effective tool for treating gout and hyperuricemia. Extracellular synthesis of this enzyme further promotes its scalability at an affordable cost. Moreover, lesser regulatory limitations for the non-genetically modified strain UR1 enhance its accessibility for clinical use.
This study’s findings could facilitate large-scale uricase production with strain UR1. The optimization of medium composition and growth conditions provides guidelines for inexpensive uricase production at the industrial level. Uricase stability at various temperatures and pH levels further improves its suitability for a range of industrial applications.
Though this study confirms the uricase synthesis efficacy of strain UR1, further investigations are necessary for its enhanced applicability. Whole-genome sequencing (WGS) could elaborate on the genetic basis of uricase synthesis to enable specific genetic alterations for improved stability and yield. Moreover, advanced bioprocessing approaches (fed-batch fermentation) could also improve industrialscale enzyme yield. The therapeutic potential of uricase should also be clinically analyzed through efficacy and immunogenicity assessment along with the exploration of influential cofactors for enhanced activity in diverse formulations and improved shelf-life.
The study highlights the uricase synthesis potential of Alcaligenes spp. strain UR1. It also addresses key gaps in previous uricase production techniques and optimizes and analyzes the enzyme’s properties. Moreover, the results provide a foundation for industrial and therapeutic applications of strain UR1. Future investigations should focus on enhancing uricase production and clinical applications through advanced molecular and genetic analyses.